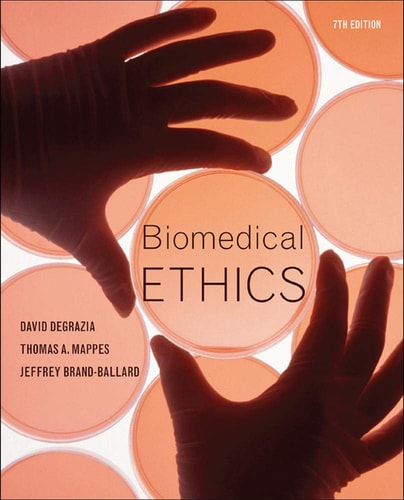

Sale!
Biomedical Ethics (7th Edition)
Original price was: $39.99.$24.99Current price is: $24.99. $19.99
Download Biomedical Ethics (7th Edition) written by Thomas A. Mappes in PDF format. This book is under the category AO and bearing the isbn13 numbers 9780073407456/9780073407456. You may reffer the table below for additional details of the book. We do NOT provide access codes, we provide eBooks ONLY. Instant access will be granted as soon as you complete the payment. p>
Additional information
| book-author | Thomas A. Mappes |
|---|---|
| publisher | McGraw-Hill Education |
| file-type | |
| language | en |
| year | 2010 |
| isbn13 | 9780073407456 |
| isbn10 | 9780073407456 |
| pages | 752 |
Be the first to review “Biomedical Ethics (7th Edition)” Cancel reply
Related products
- Sale!

Genetics Essentials: Concepts and Connections (5th Edition)
Original price was: $39.99.$24.99Current price is: $24.99.$19.99 - Sale!

Theoretical Perspectives for Direct Social Work Practice, Fourth Edition: A Generalist-Eclectic Approach (4th Edition)
Original price was: $39.99.$24.99Current price is: $24.99.$19.99 - Sale!

Design Basics (9th Edition)
Original price was: $39.99.$24.99Current price is: $24.99.$19.99 - Sale!

Entomology and Pest Management (4th Edition) (Subsequent Edition)
Original price was: $39.99.$24.99Current price is: $24.99.$19.99
Reviews
There are no reviews yet.